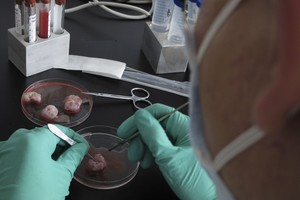
Kinai šiurpina: masiškai klonuos gyvūnus, ateityje – ir žmones

Daktaras Hwang Woo Sukas yra, ko gero, garsiausias Pietų Korėjos žmogus.
Šis 64-erių mokslininkas pirmasis pasaulyje klonavo šunį, katę, kojotą ir stirną.
O dabar jis turi daug ambicingesnį siekį: į pasaulį sugrąžinti mamutą – gyvūną, kuris išnyko prieš tūkstančius metų.

A.Kumžos nuotr
Pakvietė į operacinę
Iš „Sooam Biotech“ instituto lifto iššoka žvalus ir linksmas vyriškis, panašesnis į Holivudo aktorių nei į garsų mokslininką.
Jokios puikybės ar gėrėjimosi savimi, tačiau jauti, kad po žaisminga bendravimo maniera slypi nepalenkiama valia ir galingos energijos kamuolys.
Daktarui – per šešiasdešimt, o jo komanda, surinkta iš viso pasaulio, – perpus jaunesnė.
Jie linksmi ir atsipalaidavę, bet viskas vyksta stebėtinai sklandžiai, be jokių pašalinių emocijų ar nereikalingo šurmulio.
Daktaras pakviečia į operacinę. Mergina mikroskopu tyrinėja ląstelę, mes viską matome ekrane. Ji preciziškai praduria somatinės ląstelės apvalką ir paima genetinę informaciją. Lygiai taip pat tiksliai perneša ją į kitą ląstelę, kuri bus implantuota surogatinei kalei.
Tai atliks pats Hwang Woo Sukas. Jau šimtus kartų daryta operacija, bet kiekvieną kartą jaudinanti. Žirklės, elektrinis pincetas. Ant operacinio stalo – surogatinė kalė.
Pasaulis laukia stebuklo: mokslininkas klonuoja šunis, ruošiasi mamutui

A.Kumžos nuotr
Daktaras ramiai užsimauna pirštines, užsideda kepuraitę, paima į ranką skalpelį. Keturi jauni pagalbininkai akylai stebi savo guru judesius, kažkuris nervingai pirštais barbena į stalą.
Nuo mikroskopo atnešama gyvybės informacija. Mokslininkas tiksliais judesiais pradeda operaciją, kuri užtrunka vos kelias minutes.
Gydo ir sudužusias širdis
Hwang Woo Sukas visą laiką lenktyniavo su JAV mokslininkais, kas pirmas klonuos šunį. Laimėjo korėjietis. Šiuo metu jau klonuota daugiau kaip 900 šių keturkojų.
Klonuoti šunys gali daugintis, jie laimi konkursus ir lenktynes, dirba policijoje, oro uostuose, gelbėjimo tarnybose.
Laboratorijos darbuotojai šypsodamiesi sako: „Mes ne tik klonuojame, mes gydome sudužusias širdis.“
Seule esanti laboratorija beveik kasdien gauna užsakymų iš daugelio pasaulio šalių klonuoti šunis. Daktaras rodo ką tik pasaulį išvydusį šuniuką, klonuotą vieno Arabijos pusiasalio princo užsakymu. Greta – dvi Sibiro laikos, kurios bus padovanotos Jakutijos medžiotojams.
Jei ne korėjiečių mokslininkų pagalba, ši legendinė Sibiro šunų veislė būtų išnykusi.

A.Kumžos nuotr.
Atgaivinti ypač sudėtinga
Hwang Woo Sukas neabejoja, kad jam pasiseks iš ledyne įšalusios ląstelės rekonstruoti ir žmonijos apyaušrio gyvūną.
Sibire mokslininkai rado prieš tūkstantmečius užšalusių mamuto audinių, kurių ląstelės turi reikalingos genetinės informacijos.
Kalbėdamas su „Lietuvos rytu“ Pietų Korėjos mokslininkas pripažino, kad mamutų atgaivinimas yra ypač sudėtingas.
Pirmiausia reikia surasti ir atgabenti į laboratoriją tūkstančius metų ledynuose išgulėjusias mamuto ląsteles.
Jas atgaivinę mokslininkai mėgins sukurti embrioninį kloną, naudodami Azijos dramblio moteriškąją ląstelę.
Galų gale klonuotą embrioną Hwang Woo Sukas įsodins surogatinei Azijos dramblio patelei ir lauks nėštumo.
Daktaras jau galvoja ne tik apie mamutų, bet ir kitų išnykusių gyvūnų atgaivinimą.

A.Kumžos nuotr
Ekspedicijos į Sibirą
Kai prieš penkerius metus korėjietis pradėjo mamutų sugrąžinimo projektą, kitose šalyse – JAV, Vokietijoje, Japonijoje, Prancūzijoje ir Rusijoje – šis darbas jau buvo dirbamas visą dešimtmetį.
Hwang Woo Suką bendradarbiauti pakvietė Rusijos Šiaurės Rytų federalinis universitetas, kurio mokslininkai gerai žinojo apie unikalius klonavimo darbus Pietų Korėjoje.
Kaip tik tuo metu Hwang Woo Sukas pirmasis pasaulyje sėkmingai pradėjo klonuoti kojotus.
Korėjiečiai priėmė Sibiro mokslininkų kvietimą ir šiuo metu jau yra surengę šešias bendras ekspedicijas.

A.Kumžos nuotr
Svarbiausia – tvirtai tikėti
„Matyt, daug kas sako jums, kad klonuoti mamuto neįmanoma?“ – paklausiau Hwang Woo Suko.
„Taip, kai kurie mokslininkai ir žurnalistai kalba, kad tai tuščias laiko gaišimas ir apgaulė. Bet mes drąsiai žiūrime į kliūtis, netgi tada, kai jos atrodo neįveikiamos.
Abejojantiems sėkme norėčiau pasakyti, kad mokslo keliu visada einame neturėdami garantijų. Toks yra mokslininko gyvenimas ir pašaukimas.
Šis pašaukimas yra priežastis, kuri mus veda pirmyn, kad kuo greičiau ateitų diena, kai bus klonuotas mamutas“, – kalbėjo korėjietis mokslininkas.
Daktaras neprognozavo, kada pamatysime žingsniuojantį mamutą, bet iš jo ryžto matyti, kad ilgai laukti nereikės.„Kai buvau mažas, visi aplink kartojo, kad kelionė į Mėnulį yra apgaulė ir neįmanomas žygis. Bet kai man sukako trisdešimt, JAV astronautas Neilas Armstrongas jau žengė Mėnulio paviršiumi.
Mobilusis telefonas mano vaikystėje irgi atrodė neįmanomas, bet šiandien jis yra įprastas daiktas bet kuriame Žemės taške.
Įsivaizduokime, kad man, tada mažam berniukui, kažkas visa tai pasakoja, o aš netikiu!
Į ką aš tada būčiau panašus? Į tuos, kurie šiandien aiškina, kad mamutų projektas neįmanomas dėl mokslinių ar socialinių priežasčių“, – šypsodamasis pasakojo daktaras.
Klonavimas yra matomoji ledkalnio viršūnė. Mažiau pastebimi sudėtingi tyrimai, kurių rezultatai padės įveikti Alzheimerio ligą, vėžį, diabetą, kitas baisias ligas.
Neseniai Hwang Woo Suko institutas, remdamasis savo atradimais, pradėjo gaminti itin veiksmingą kosmetiką „Dracell“, kuri netrukus pasirodys ir Europoje.
Skundikai apkartino gyvenimą
Hwang Woo Suko darbai embrioninių kamieninių ląstelių srityje prieš dešimt metų pelnė jam tarptautinę šlovę.
Pietų Korėjoje jis tapo nacionaliniu didvyriu, buvo paskelbtas geriausiu mokslininku, jo garbei buvo išleistas pašto ženklas.
Korėjos oro linijos daktarui suteikė teisę dešimt metų nemokamai skraidyti pirmąja klase.
Tačiau akimirksniu įvyko griūtis, kai 2004 metais jis paskelbė apie savo naujausią sensacingą darbą – klonavo žmogaus embrioninę kamieninę ląstelę.
Kuo labiau mokslininkas artėjo prie žmogaus, tuo tamsesni debesys tvenkėsi virš jo galvos. Tada profesorių užklupo bėdos, prilygstančios žemės drebėjimui.

A.Kumžos nuotr
Jis buvo saviškių apskųstas, o teisėsaugos apkaltintas įvairiais nusižengimais ir neetiškais sprendimais.
Praėjus dešimčiai metų išaiškėjo, kad nusižengimų būta, bet už tai atsakingas ne jis, o klinika, su kuria bendradarbiavo.
Dabar tai mažai kam rūpi, o tada ši istorija įelektrino visuomenę, padalijo ją į dvi nesutaikomas dalis.
Profesoriui teko išeiti iš Seulo nacionalinio universiteto, jam buvo uždrausta atlikti bandymus su žmogaus ląstelėmis.
Bendradarbiai nuklojo kelią į daktaro laboratoriją rožių žiedais, bet ten jis niekada nebegrįžo.
Nepaisydamas galingų atakų Hwang Woo Sukas pirmasis pasaulyje klonavo šunį.
Vyriausybė mokslininkui leido įkurti naują institutą. Dvidešimt mokslininkų liko su juo, kitus sukvietė iš garsiausių pasaulio genetikos laboratorijų.
Padėjo Rytų išmintis
Kalbėdamas su „Lietuvos rytu“ mokslininkas atskleidė, kas jam padeda siekti tikslo.
Prieš trisdešimt metų Hwang Woo Sukas, tada dar mažai kam žinomas Seulo universiteto dėstytojas, atėjo į kuksando centrą.
Kuksando – tai labai senas korėjietiškas mokymas, padedantis žmogui atkurti energiją ir visą gyvybės potencialą.
Pirmasis jo kuksando mokytojas buvo meistras Jin Mokas, šiuo metu globojantis ir Lietuvos nacionalinį kuksando centrą.
Susiję straipsniai
Meistras prisiminė, kad naujasis studentas sparčiai tobulėjo, nes buvo atkaklus ir drausmingas.
Trejus metus Hwang Woo Sukas mokėsi pas Jin Moką, o paskui kasdien praktikavo savarankiškai, tik retkarčiais paskambindavo pasitarti.
Daktaras prisipažino, kad ilgametė kuksando praktika išugdė ryžtą nepasiduoti ir atsilaikyti prieš didžiausias kliūtis. Be šio mokymo jis nebūtų atlaikęs išbandymų, kuriuos teko patirti.
Pirmasis smūgis buvo, kai tik pradėjus mokslininko karjerą jam diagnozavo hepatomą (kepenų vėžys. – Red.).
„Mano ateitis tapo neaiški, jaučiausi beviltiškai.
Būtent tada aptikau informacijos apie proto ir kūno lavinimo sistemą kuksando.
Dabar jau ketvirtas dešimtmetis esu paniręs į šį mokymą. Per tą laiką puolė įvairios ligos, bet nė viena nebuvo pajėgi manęs pažeisti. Esu sveikas ir fiziškai, ir dvasiškai“, – „Lietuvos rytui“ kalbėjo Hwang Woo Sukas.
Garsusis klonuotojas įsitikinęs, kad visą tą laiką jo sveikatą saugojo kuksando, kuris gali padėti ir kitiems.
Pirmykščiai drambliai vaikščiojo ir Vilniuje
Mamutai buvo panašūs į Indijos dramblius, tik apžėlę tankiais ir ilgais gaurais. Jie buvo prisitaikę gyventi šalto klimato sąlygomis, buvo paplitę beveik visame Šiaurės pusrutulyje.
Šie straubliniai žinduoliai būdavo 3,6 m ūgio, kūnas – 4 m ilgio. Galėjo sverti iki 7 tonų, o gyvenimo trukmė siekė iki 130 metų.
Tiesa, daug jų išnyko dėl pirmųjų žmonių veiklos. Vėlyvojo paleolito laikais žmonės medžiojo mamutus, maitinosi jų mėsa, odą ir kaulus naudojo kaip statybinę medžiagą, gamino darbo įrankius, šildydavosi kūrendami riebalus.
Mamutai galutinai išnyko prieš 4 tūkst. metų. Mokslininkai iki šiol ginčijasi, kodėl tai įvyko. Vieni laikosi nuomonės, kad tai atsitiko pasikeitus klimatui, – kartu išnyko ir šių gyvūnų maistas. Kiti tikina, kad dėl šių žinduolių išnykimo kaltas žmogus ir jo veikla. Dėl gauruotų dramblių išnykimo dar kiti mokslininkai kaltina virusus.
Lietuvos teritorijoje mamutai gyveno nuo 74 tūkst. iki 24 tūkst. metų prieš Kristų. Greičiausiai mamutams su žmonėmis neteko susidurti, nes pirmųjų gyventojų apsigyvenimas dabartinėje Lietuvoje datuojamas apie 10 tūkst. metų prieš Kristų, o mamutai čia gyvenę keliolika tūkstantmečių anksčiau.
1957 m. Vilniuje, Antakalnio mikrorajono Smėlio gatvėje, tvarkydami kanalizaciją darbininkai 3,5 m gylyje aptiko didelių kaulų, kurie trukdė tęsti darbus. Jie buvo sukapoti ir sumesti duobės pakrašty. Apie radinį sužinoję Istorijos instituto darbuotojai surinko tuos kaulus ir išsivežė. Nustačius, kad tai mamuto kojos kaulai, nutarta dar pakasinėti vietą, kurioje jie buvo aptikti. 4 m gylyje rastos dvi iltys (durklai), apatinis žandikaulis, stuburo narelis, abi dešinės kojos. Dramblio iltis dabar galima apžiūrėti Tado Ivanausko muziejuje Kaune.
Klonai ir jų istorijos
Klonavimas yra genetiškai tapačių ląstelių ar individų gavimas nelytinio dauginimo būdu. Gamtoje klonavimo būdu organizmai dauginasi ir natūraliai, pavyzdžiui, bakterijos. Augalai, kurie dauginasi vegetatyviniu būdu, t.y. naujas augalas išsivysto iš motininio augalo lapų, ūglių ar šaknų, vadinami klonais. Klonai žinomi ir gyvūnų pasaulyje. Neseniai nustatyta, kad skruzdėlės Wasmannia auropunctata dauginasi klonavimo būdu.
Pirmieji bandymai klonuoti prasidėjo prieš devynis dešimtmečius. 1928 m. vokiečių mokslininkas Hansas Spemannas (1869–1941) perkėlė ląstelės branduolį į kitą ląstelę. Tai buvo pirmasis žingsnis klonavimo link.
Susiję straipsniai
1952 m. amerikiečių mokslininkai Robertas Briggsas (1911–1983) ir Thomas Kingas (1921–2000) sukūrė branduolio perkėlimo technologiją. Jie varlės embriono ląstelės branduolį perkėlė į neapvaisintą kiaušialąstę, iš kurios buvo pašalintas branduolys, ir klonavo varlę. Vėliau varlė klonuota į kiaušialąstę perkėlus suaugusios varlės ląstelės branduolį.
1996 m. Škotijoje, Roslino institute, pasaulį išvydo avis Doli – pirmasis žinduolis, klonuotas iš somatinės ląstelės. Iš 277 klonavimo bandymų pavyko tik šis vienas, bet jis įrodė, kad iš suaugusio organizmo ląstelės galima užauginti žinduolį. Ši garsiausia pasaulyje avis gyveno šiek tiek ilgiau nei šešerius metus ir per šį laiką atsivedė šešis palikuonis.

A.Kumžos nuotr.
Ji sirgo, todėl 2003 m. buvo užmigdyta. Vieni mokslininkai mano, kad ligos, užpuolusios avį Doli, nesusijusios su klonavimu, kiti – kad vos tik atsivestos Doli genetinis amžius jau buvo šešeri metai – kaip ir avies, iš kurios ji klonuota.
Be avies Doli, vėliau atlikta daug kitų bandymų klonuoti gyvūnus. Bene sėkmingiausi įvykdyti Pietų Korėjoje įsikūrusioje bioinžinerijos bendrovėje „Sooam Biotech Research Foundation“, kurią įkūrė Hwang Woo Sukas. O vienas dažniausių šiomis dienomis užsakymų – klonuoti augintinį.